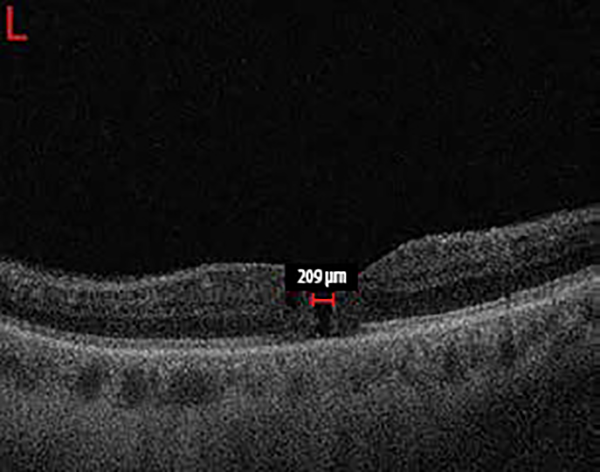
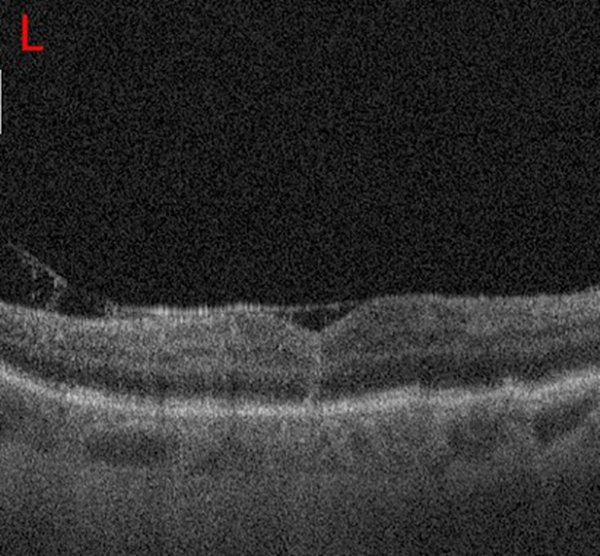

Figura 1. La OCT prequirúrgica de mácula izquierda muestra la presencia de un agujero macular de espesor completo en estadio II, con espacio quístico intrarretinal en el margen del orificio al agujero.
CASO CLÍNICO
Agujero macular bilateral en síndrome de Alport
Juan Manuel López, Mariano Irós
Instituto de Microcirugía Ocular Córdoba (IMOC), Córdoba, Argentina
Recibido: 21 de julio de 2020.
Aceptado: 13 de octubre de 2020.
Autor corresponsal
Dr. Juan Manuel López
ismedok@hotmail.com
Oftalmol Clin Exp (ISSN 1851-2658)
2021; 14(1): 42-48.
Conflicto de interés
Los autores declaran no tener ningún conflicto de intereses.
RESUMEN
El síndrome de Alport es un desorden genético caracterizado por la mutación de genes que codifican el colágeno tipo IV, principal componente de la membrana limitante interna, estructura identificada en el complejo membrana basal del epitelio pigmentario de la retina y membrana de Bruch. Esta alteración puede condicionar la predisposición a la aparición de agujeros maculares.
Objetivo: Describir la dificultad y variantes en el abordaje quirúrgico del agujero macular bilateral por síndrome de Alport.
Caso clínico: Se informa el caso de un paciente masculino de 46 años con diagnóstico de síndrome de Alport que consultó por disminución visual en ojo izquierdo de 20 días de evolución. Se diagnosticó agujero macular en ese ojo que se trató quirúrgicamente. A posteriori presentó compromiso del ojo congénere por el mismo cuadro que fue tratado bajo técnica quirúrgica de flap invertido.
Conclusión: Se obtuvo un óptimo resultado en la resolución del agujero macular asociado al síndrome de Alport bajo la técnica de VPP con flap invertido, consiguiendo en los primeros días posquirúrgicos un cierre anatómico completo del agujero macular luego de la primera intervención. Por esta razón se ve a esta técnica como una opción efectiva en el cierre estructural del AM con cambios visuales y estructurales positivos.
Palabras claves: síndrome de Alport, agujero macular, vitrectomía, flap invertido, enfermedad hereditaria.
Bilateral macular hole in Alport syndrome
ABSTRACT
Objective: To describe the difficulties of the surgical approach to close bilateral macular holes due to Alport syndrome as well as its different options.
Clinical case: Case report of a 46-year-old male patient diagnosed with Alport syndrome complaining of visual loss of 20 days of evolution in the left eye. Diagnosis of macular hole in that eye was made and the patient received surgical treatment. He subsequently developed involvement of the fellow eye due to the same picture for which he underwent a surgical procedure applying the inverted flap technique.
Conclusion: Resolution of the macular hole associated with Alport syndrome was achieved with optimal results using PPV with inverted flap technique, with full anatomical closure of the macular hole on the first postoperative days after the first procedure. For this reason, this technique is considered as an effective option for structural closure of MH with positive visual and structural changes.
Keywords: Alport syndrome, macular hole, vitrectomy, inverted flap, hereditary disease.
Buraco macular bilateral em síndrome de Alport
RESUMO
Objetivo: Descrever a dificuldade e variantes na abordagem cirúrgico do buraco macular bilateral por síndrome de Alport.
Caso clínico: informa-se o caso de um paciente masculino de 46 anos com diagnóstico de síndrome de Alport que consultou por diminuição visual no olho esquerdo de 20 dias de evolução. Diagnosticou buraco macular nesse olho que foi tratado cirurgicamente. Depois, apresentou compromisso do olho congénere pelo mesmo quadro que foi tratado sob técnica cirúrgica de flap invertido.
Conclusão: Obteve-se um ótimo resultado na resolução do buraco macular associado a síndrome de Alport sob a técnica de VPP com flap invertido, conseguindo nos primeiros dias pós-cirúrgicos um fechamento anatómico completo do buraco macular logo da primeira intervenção. Por esse motivo, vemos essa técnica como uma opção efetiva no fechamento estrutural do AM com câmbios visuais e estruturais positivos.
Palavras chave: síndrome de Alport, buraco macular, vitrectomia, flap invertido, doença hereditária.
INTRODUCCIÓN
El síndrome de Alport (SA) fue descripto en 1927 por Arthue Cecil Alport1 y es un trastorno hereditario caracterizado por insuficiencia renal progresiva, discapacidad auditiva y cambios oculares. Es clínica y genéticamente heterogéneo y en su historia natural, la enfermedad renal progresa de hematuria microscópica a proteinuria y finalmente a insuficiencia renal progresiva.
El SA es una enfermedad hereditaria que aparece en uno de cada 5.000–50.000 recién nacidos y con presentación más frecuente en el sexo masculino2-3.
Existen tres formas genéticas, siendo la más frecuente (alrededor del 80-85%) la ligada al cromosoma X dominante y originada por mutaciones en el gen COL4A5. En los casos restantes puede heredarse de forma autosómica recesiva o raramente de forma autosómica dominante, en las cuales principalmente la condición es causada por mutaciones en los genes COL4A3 o COL4A44.
El SA es causado por un defecto hereditario en el colágeno tipo IV, un material estructural expresado en las membranas basales de la cóclea, glomérulo renal y estructuras oculares, lo que ocasiona hipoacusia neurosensorial y nefropatía con evolución a fallo renal precoz. Las alteraciones oculares aparecen en el 92% de los casos, siendo los hallazgos más característicos el lenticono anterior y la retinopatía en flecos (punto-mancha)5. A nivel retinal, la existencia de un agujero macular (AM) asociado al SA es un hallazgo poco usual.
En este reporte de caso describiremos un paciente masculino con un historial oftalmológico de agujeros maculares bilaterales producto del síndrome de Alport.
REPORTE DE CASO
Paciente masculino de 46 años con diagnóstico de síndrome de Alport (SA) consultó por disminución de la agudeza visual (AV) en su ojo izquierdo (OI) de 20 días de evolución.
Estaba en tratamiento con audífonos por hipoacusia sensorial, sin antecedentes quirúrgicos relevantes. Al momento de la consulta se encontró bajo tratamiento farmacológico con enalapril, hidroclorotiazida y alprazolam. Antecedentes familiares sin diagnóstico de SA.
En cuanto a sus antecedentes personales oftalmológicos refirió cirugía refractiva para corrección de miopía en ambos ojos (AO) realizada en 2003 bajo técnica LASIK y el diagnóstico de maculopatía en AO hace 2 años.
Al examen oftalmológico se obtuvo una AV en su ojo derecho (OD) de 6/10 sin corrección (SC) y 1/10 (SC) en su OI.
Bajo observación del segmento anterior mediante lámpara de hendidura se evidenció en ambos ojos: córneas con cicatriz de excímer láser, cristalinos transparentes y resto sin particularidades. La tonometría ocular evaluada con tonómetro modelo Haag-Streit Perkins fue de 12 mmHg en OD y 14 mmHg en OI. Sin defecto pupilar aferente relativo.
El fondo de ojos reveló algunas drusas pequeñas en zona perifoveolar, retina periférica y nervio óptico normales en AO; en OI se observó un agujero macular (AM) de espesor completo.
Se realizó tomografía de coherencia óptica (OCT) en OI con equipo Spectral Domain OCT Copernicus (Optopol Technology, Zawiercie, Polonia) que verificó la presencia de AM en estadio II, con un diámetro de 209 μm, sin edema ni eversión de los bordes del agujero (fig. 1).
Figura 1. La OCT prequirúrgica de mácula izquierda muestra la presencia de un agujero macular de espesor completo en estadio II, con espacio quístico intrarretinal en el margen del orificio al agujero.
Se llevó a cabo vitrectomía vía pars plana (VPP) con calibre 23 G, despegamiento total de hialoides posterior (HP) asistida por triamcinolona intravítrea y disección de membrana limitante interna (MLI) bajo coloración con azul brillante; posteriormente se realizó taponaje bajo introducción intravítrea (IV) de gas expansible como el hexafluoruro de azufre (SF6) al 20%. Se indicó tratamiento farmacológico y reposo en decúbito prono durante 7 días.
A los 14 días de dicha cirugía se vuelve a reintervenir el OI por falta de cierre del AM (fig. 2).
Esta vez se procedió con el mismo abordaje quirúrgico anteriormente descripto y se optó por realizar masajes sobre los bordes del agujero macular con instrumental finesse flexible loop (Alcon/Finesse Flex Loop 23 G; Vernier-Geneva, Suiza), para luego colocar aceite de silicón (AS) como agente de taponaje.

Figura 2. Mediante OCT se observa la falta de coalescencia de los bordes luego de 7 días de la intervención quirúrgica en el AM del OI.
Los controles posteriores se encontraron dentro de los parámetros posquirúrgicos esperados y luego de 10 días de la intervención se realizó seguimiento con OCT observando en este el cierre total del AM (fig. 3).
Figura 3. OCT del OI donde se observa el cierre del AM después de la VPP con masajes de bordes y colocación de aceite de silicón.
Luego de tres meses de la última intervención en OI se decide realizar facoemulsificación con colocación de lente intraocular y extracción de AS. Seguimientos posteriores con parámetros de retina estables.
A los 21 días posfacoemulsificacion con extracción de AS en OI, concurrió por disminución visual nuevamente en su OI. Al examen con OCT se observó reapertura del AM en OI, esta vez con un diámetro de 269 micras y quistes intrarretinales ubicados en los bordes de dicha lesión (fig. 4).

Figura 4. Agujero macular en OI con un tamaño de 269 micras mediante OCT.
Se realizó VPP calibre 25 G, masajes sobre bordes del AM y posterior colocación de AS. Controles posquirúrgicos en parámetros conservados con AM cerrado en la primera semana.
Luego de 6 meses se decidió la extracción del AS en OI mediante VPP con calibre 23 G, además se realizó endofotocoagulación láser alrededor de micro desgarros retinales periféricos y posteriormente se colocó taponaje con gas (SF6 20%).
A los cuatro meses posteriores a la última intervención quirúrgica en OI concurrió por disminución de AV y escotoma central en su OD. Se realizó examen oftalmológico con AV de 1/10 SC y 1/10 CE en OD, y 4/10 SC y 6 /10 CE en OI. Al fondo de ojos se evidenció un agujero macular AM de espesor completo en el OD.
Se realizó OCT en OD que verificó la presencia de AM grande con un diámetro de 538 micras, en estadio IV, hiperreflectividad en capas internas retinianas y cambios quísticos en los tejidos adyacentes (fig. 5).

Figura 5. Mediante OCT del OD se observó AM con un tamaño de 538 mcm, con espacios quísticos intrarretinales y eversión de los bordes.
A la semana de diagnosticado el cuadro en su OD se llevó a cabo VPP con calibre 23 G bajo técnica de flap invertido.
Se procedió a la disección de hialoides posterior asistida por triamcinolona intravítrea y de membrana limitante interna bajo tinción con azul brillante sobre el aérea perifoveal, pelado de membrana limitante interna desde temporal a nasal y desde nasal a temporal para colocar el remanente dentro del agujero macular. Posteriormente se realizó crioterapia de hora 11 a 6 tras la visualización intraquirúrgica de un desprendimiento de retina plano y para luego tamponar con gas SF6 al 20%.
Controles posteriores dentro de los parámetros posquirúrgicos esperados. El agujero macular cerró dentro de los primeros 10 días posteriores a la intervención quirúrgica mediante seguimiento con OCT.
Luego de aproximadamente 7 meses de su última intervención en OD y 11 meses de su última intervención en OI, al examen oftalmológico presentó una AV en OD de 6/10 (SC) y OI de 4/10 (SC). A nivel de polo posterior la retina de ambos ojos permanece en características conservada.
Se realizó OCT control en ambos ojos OD (R) OI (L) (fig. 6).
Figura 6. Último OCT realizado donde se observa la resolución quirúrgica final con sellado de ambos AM.
DISCUSIÓN
Las características oculares que se describen en el SA incluyen anomalías que afectan córnea, iris, cristalino y retina. Entre estos hallazgos los reportados con mayor frecuencia son la retinopatía perimacular —en flecos– (18%-92%) y el lenticono anterior (12%-47%)5.
La maculopatía en el SA es uno de los hallazgos más frecuentes, siendo más diagnosticado en el hombre que en la mujer en cuadros autosómicos recesivos. Su característica varía desde puntos dispersos y manchas temporales hacia la mácula, llevando a la formación de un anillo perimacular con puntos densos entre el perímetro foveal y las arcadas vasculares, que producen un reflejo anormal que contrasta bruscamente con el de una retina normal (reflejo macular opaco o signo del rombo). Esta retinopatía no está asociada con discapacidad visual y no es necesario realizar tratamiento alguno ante su diagnóstico.
Por otra parte, los agujeros maculares son una anomalía poco común y llamativa para este síndrome, pero que amenaza la visión. Los primeros reportes datan del año 1992 por Kaimbo y Moussa6.
Los agujeros maculares en el síndrome de Alport pueden aparecer como lamelares, de espesor completo o gigantes.
El agujero macular asociado al síndrome de Alport deberá ser diferenciado de los agujeros maculares de origen idiopáticos; esta diferencia radica por su tendencia de ser de mayor tamaño, presentación en edades más tempranas y su dificultad en la reparación quirúrgica. Esto deberá tenerse en cuenta para la planificación del tratamiento y discusión del pronóstico.
Su etiología sigue siendo discutida por diferentes teorías que se centran en la anormal síntesis del colágeno tipo IV de las membranas basales (membrana limitante interna y complejo de membrana basal del epitelio pigmentario retinal —membrana de Bruch— coroides).
La membrana limitante interna (MLI) es una membrana basal formada por las placas terminales de las células de Müller. La membrana de Bruch, por su parte, tiene la función de regular el paso de nutrientes y metabolitos del epitelio pigmentario retinal (EPR) y coriocapilaris subyacente. La adherencia normal entre la membrana de Bruch y el EPR es mantenida por fibras de colágeno.
Mete y colaboradores han planteado la hipótesis del irregular paso de fluido a través de una membrana de Bruch estructuralmente anormal produciendo así un incremento en la permeabilidad y con ello la formación de cavitaciones microquísticas en las capas internas de la retina, especialmente en la plexiforme externa (Henlens)7. Las paredes de estos quistes pueden romperse creando un quiste confluente y eventualmente su ruptura produciendo un AM.
Por otra parte Shah y colaboradores refieren que la anormalidad en la MLI juega un papel importante en la formación del AM, ya que su estructura —basada en fibrillas de colágeno, proteoglicanos, membranas basales, membranas plasmáticas de las células de Müller y células gliales— produce un debilitamiento estructural de la retina interna que se vuelve vulnerable a la rotura por tracción del vítreo, como así también que la proliferación focal de las células de Müller puedan crear tracciones secundarias a través de una adherencia vitreorretinal anormal8.
La gran dificultad en el pelado de la MLI durante las intervenciones quirúrgicas de AM en pacientes con SA sugiere la participación de esta estructura en la patogenia. Miller et al. describen la dificultad de la intervención quirúrgica en una paciente femenina con SA quien padecía AM gigantes en ambos ojos (mayor a 1.500 micras de diámetro), su dificultad radicó en intentos vigorosos para eliminar el vítreo cortical posterior y trastornos al realizar el peeling de MLI por su extrema adherencia hialoidea9.
Por otro lado Ozdek y colaboradores propusieron que una lesión isquémica en la fóvea por un fenómeno de vasoconstricción en pacientes con nefropatía hipertensiva crónica podría conducir al agrandamiento del agujero macular10.
Las técnicas quirúrgicas para el tratamiento del AM han ido depurándose a través de los años. Dentro de los distintos avances se ha permitido aumentar la tasa de éxito tanto anatómico como visual y se destaca la acción de pelar la membrana limitante interna y el advenimiento de tinciones vitales como el azul brillante, que permite una visualización completa de esa membrana, lo que facilita su separación de la retina.
La VPP mínimamente invasiva combinada con el pelado de la membrana limitante interna hoy en día es la técnica más popular para el tratamiento del agujero macular.
Sin embargo, con el desarrollo del OCT, el continuo estudio de la interfaz vitreorretinal y la búsqueda de mejoras en cuanto a la tasa de cierre del AM y de la AV postoperatoria especialmente en los AM grandes y refractarios, llevó a los cirujanos del segmento posterior a la búsqueda de nuevas técnicas quirúrgicas.
Michalewska y colaboradores desarrollaron una técnica que consiste en realizar unos colgajos con la misma MLI para que sirvan como tapón sobre el agujero macular, así introducen y describen una nueva técnica quirúrgica con el término de flap invertido (inverted flap) para agujeros maculares mayores de 400 micras, logrando aumentar el cierre anatómico y mejoría funcional después de una vitrectomía completa.
En la técnica de flap invertido, en lugar de eliminar completamente la MLI después de la tinción con azul brillante, se procede a dejar un remanente de MLI adherida a los márgenes del agujero macular. Este remanente de MLI se invirtió al revés para cubrir el agujero macular11.
CONCLUSIÓN
Creemos que ambas teorías fisiopatogénicas descriptas no son mutuamente excluyentes y tanto la debilidad en las membranas basales como una interfaz vitreorretinal anormal contribuyen a la dificultad quirúrgica.
En el presente reporte de caso hemos obtenido un óptimo resultado para la resolución del AM bajo la técnica de VPP con flap invertido de la MLI, obteniendo un cierre anatómico del agujero macular en la primera intervención quirúrgica. Por lo que creemos que esta técnica es una opción efectiva en el cierre estructural del AM con cambios visuales positivos.
Esperamos que luego de este informe se pueda incentivar y promover su realización para obtener un estudio con mayor número de casos, como así también del tiempo de seguimiento que permita evaluar a futuro el impacto de la técnica en los agujeros maculares relacionados al síndrome de Alport.
REFERENCIAS
1. Alport AC. Hereditary familial congenital heamorrhagic nephritis. Br Med J 1927; 1(3454): 504-506.
2. Hasstedt SJ, Atkin CL. X-linked inheritance of Alport syndrome: family P revisited. Am J Hum Genet 1983; 35: 1241-1251.
3. Levy M, Feingold J. Estimating prevalence in single-gene kidney diseases progressing to renal failure. Kidney Int 2000; 58: 925-943.
4. Zhang Y, Ding J. Renal, auricular, and ocular outcomes of Alport syndrome and their current management. Pediatr Nephrol 2018; 33: 1309-1316.
5. Gelisken O, Hendrikse F, Schröder CH, Berden JH. Retinal abnormalities in Alport’s syndrome. Acta Ophthalmol (Copenh) 1988; 66: 713-717.
6. Kaimbo K, Moussa G. Le lenticône antérieur, évoquant un syndrome d’Alport: a propos de la première observation zaïroise. J Fr Ophtalmol 1992; 15: 493-496.
7. Mete UO, Karaaslan C, Ozbilgin MK et al. Alport’s syndrome with bilateral macular hole. Acta Ophthalmol Scand 1996; 74: 77-80.
8. Shah SN, Weinberg DV. Giant macular hole in Alport syndrome. Ophthalmic Genet 2010; 31: 94-97.
9. Miller JJ, Rodríguez FJ, Smiddy WE, Rodríguez A. Macular hole surgery in Alport syndrome. Retin Cases Brief Rep 2007; 1: 153-155.
10. Ozdek SC, Pehlivanli Z, Sari A, Hasanreisoglu B. Bilateral giant macular hole in a patient with chronic renal failure. Ophthalmic Surg Lasers Imaging 2003; 34: 480-482.
11. Michalewska Z, Michalewski J, Adelman RA, Nawrocki J. Inverted internal limiting membrane flap technique for large macular holes. Ophthalmology 2010; 117: 2018-2025.